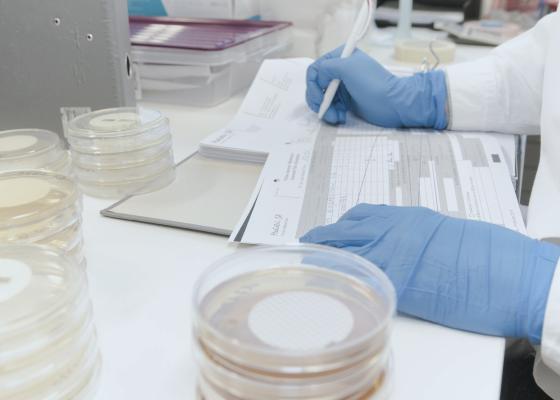

Our Headquarters
In the municipality of Domdidier, Fribourg Switzerland, Medistri's HQ and primary operations CenterPoint is a beacon of excellence.
Medistri's HQ is equipped with the infrastructure required to cater to clients worldwide in various industries, including Pharmaceutical, MedTech, BioTech, and Aerospace.
This location is strategically chosen to facilitate global logistical complexities, as it is at the intersection of the Swiss-German and French parts of the country.
The site's advantageous location includes close proximity to major transportation routes, being only 90 minutes away from Geneva's Airport and 110 minutes away from Zurich's Airport, enhancing its accessibility for international operations.
A CenterPoint for expertise, Medistri’s Domdidier Plant represents the company’s commitment to delivering the state of the art sterilisation, validation, manufacturing and laboratory services.

Our Laboratory Services
Introduced in 2007, Medistri's in-house laboratory is a full-service contract laboratory, specialised in microbiology, analytical, bioanalytical chemistry & cell biology services, custom synthesis, and R&D.
Medistri's Laboratory team will ensure that your specific needs are met to the highest standards. We ensure that your team is informed and regularly updated with detailed results throughout all stages of your project or analysis.
Our laboratory works according to ISO 17025 (current version) and is accredited since 2008 by the Swiss Accreditation Service (SAS). All testing can be performed according to European or US pharmacopeias.
The largest pharmaceutical companies in the world use Medistri's laboratory infrastructure to focus on comprehensive, innovative and fast solutions to optimise operations.

Contract Sterilisation Services
Medistri’s sterilisation infrastructure was engineered to allow you to save time and distribute your products on the market faster. We have optimised our sterilisation processes to provide you with the fastest sterilisation services available to date.
A total of 6 sterilization chambers are installed at Domdidier. Our team operates 24 hours a day, 7 days a week, sterilizing up to 90'000 pallets per year.
Our team includes world-class safety experts, all focused on the different parameters of our cycles to meet your specific needs and the complexity of your sterilised products.

Sterilisation Validation
Packaging Validation
The validation of packaging stems from the need to ensure the quality of products across the many steps in your distribution cycle: from shipping to storage. It is an increasingly common requirement for many product categories, including a strong emphasis on the packaging quality requirements for medical and pharmaceutical industries.
Medistri can validate your packaging according to ISTA 2A, ISTA 3A, ASTM D7386, ASTM D4169.
Should you fully validate your packaging system or should you simply test one particular characteristic of your sterile barrier system, Medistri laboratory is accredited and highly experienced for the most common test method provided in ISO 11607-1.

Manufacturing
Created for start-up companies and early-stage products, Medistri's manufacturing team can offer primary, secondary, and tertiary packaging solutions that fit your strategic & regulatory requirements.
Medistri's manufacturing team works with our quality team to ensure that our customers' customised single-use surgical kits are brought to market.
From manufacturing to product assembly and certification, leverage our team's expertise to find the custom solutions that fits your timeline requirements.
- Drive onto the A1 motorway.
- Take the exit for Avenches / Cudrefin.
- At the exit of the motorway, follow the direction towards Avenches / Domdidier.
- At the roundabout, take the first exit towards Z.I. Domdidier / Police / OCN.
- After 1 km, you will reach Medistri. Turn left where the visitor parking lots are located.
From Zurich Airport:
- Take the IC1 train from Geneva Airport.
- Change trains at Bern.
- Take the S52 train towards Kerzers.
- Get off at Domdidier.
- From there, it's about 1 km to Medistri.
From Geneva Airport:
- Take the IR90 train towards Brig.
- Change trains at Lausanne.
- Switch to the S9 train towards Kerzers.
- Get off at Domdidier.
- From the train station there, it's about 1 km to Medistri.
- Drive onto the A1 motorway.
- Take the exit for Avenches / Cudrefin.
- At the exit of the motorway, follow the direction towards Avenches / Domdidier.
- At the roundabout, take the first exit towards Z.I. Domdidier / Police / OCN.
- After 1 km, you will reach Medistri. Turn left where the visitor parking lots are located.
From Zurich Airport:
- Take the IC1 train from Geneva Airport.
- Change trains at Bern.
- Take the S52 train towards Kerzers.
- Get off at Domdidier.
- From there, it's about 1 km to Medistri.
From Geneva Airport:
- Take the IR90 train towards Brig.
- Change trains at Lausanne.
- Switch to the S9 train towards Kerzers.
- Get off at Domdidier.
- From the train station there, it's about 1 km to Medistri.

Medistri HQ
Rte de l’industrie 96
Zip Code 115
CH-1564 Domdidier
Switzerland